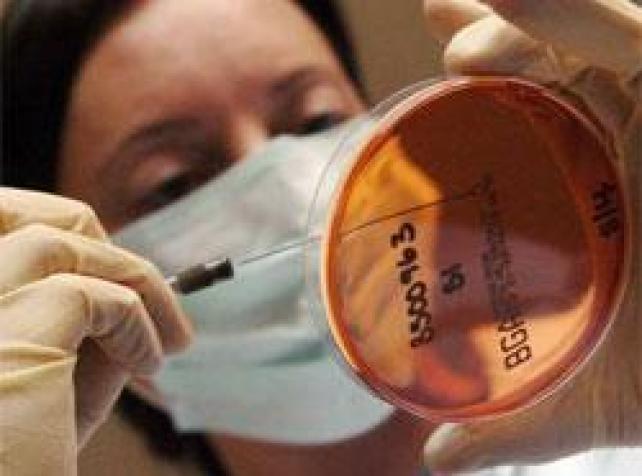
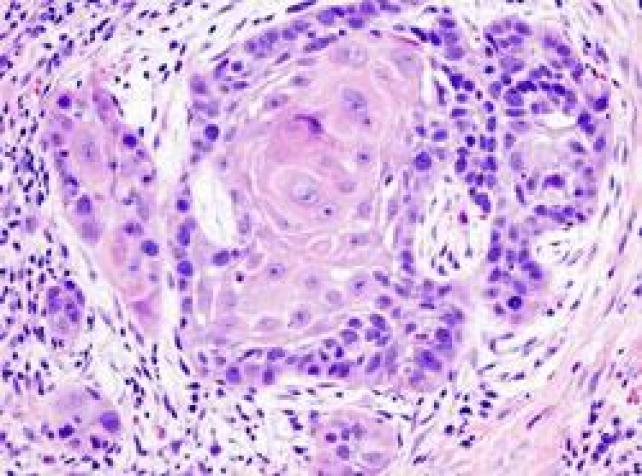

News Articles


Viagra 'could treat heart disease'
Date of Posting: 21-10-2014
Viagra's active ingredient improved the heart performance of patients in trials while having no adverse effect on blood pressure. Viagra could provide a treatment for heart disease as well as problems in the bedroom, a study suggests.[subscrib Read More...





Measles outbreak on Jetstar flight
Date of Posting: 21-10-2014
Three people who travelled with Jetstar from Indonesia to Brisbane last week have contracted measles. Passengers who flew from Indonesia to Brisbane last Wednesday are being urged to contact their GP if they feel unwell after three people on the f Read More...





Working intestine grown in lab
Date of Posting: 20-10-2014
Scientists have created the first functioning human intestine from stem cells in the laboratory, paving the way for new gut disorder treatments. Functioning human intestine has been grown from stem cells in the laboratory, paving the way to new tr Read More...

Bionic leg helps jockey ride again
Date of Posting: 17-10-2014
A bionic leg has helped a British teenage jockey who was paralysed in a car crash to walk and ride again. A teenage jockey paralysed in a car crash has amazed doctors by walking and riding again - thanks to a pioneering bionic leg.[subscribe] K Read More...





New test for patients in vegetative state
Date of Posting: 17-10-2014
Recent brain scan studies have revealed that some patients classified as vegetative are able to carry out conscious tasks. A fingerprint of consciousness has been found in the brains of patients who appear to be in a vegetative state, but remain a Read More...





Vic elective surgery rates at record high
Date of Posting: 17-10-2014
Despite hospitals failing to reach key waiting period benchmarks, a record 170,190 elective surgery patients have been treated in Victorian hospitals. A record number of elective surgery patients have passed through Victoria's hospitals, despi Read More...





Doctors treat man addicted to Google Glass
Date of Posting: 17-10-2014
A US man who wore the Google Glass headset for up to 18 hours a day has been diagnosed as having internet addiction disorder, his doctors report. An American man has been admitted into the US Navy's substance abuse program after showing signs Read More...





Forget slow weight loss advice: Aust study
Date of Posting: 17-10-2014
Dieters should forget the advice about losing weight slowly rather than shedding the kilos rapidly, according to Victorian researchers. Dieters should ignore advice that shedding the kilos slowly is better than rapid weight loss, a new study sugge Read More...





Experiences of person centred care patients' perceptions
Last Updated: 16-10-2014
Patient care models have been implemented and documented worldwide. Many studies have focused on features that hinder and facilitate the shift to such models, including the implementation process, staff involvement, resistance to new models and cultu Read More...





Pharmacists applaud immunisation move
Last Updated: 16-10-2014
Victorian pharmacists have welcomed a move that could enable them to deliver immunisations to adults as early as next year. The Legislative Council Legal and Social Issues Legislation Committee’s Inquiry into Community Pharmacy in Victoria h Read More...





GPs 'struggle to spot lung cancer'
Date of Posting: 15-10-2014
Family doctors need more help in recognising patients at a high risk of lung cancer, new research has found. One in three lung cancer sufferers die within 90 days of diagnosis, suggesting GPs are struggling to spot the early signs of the disease.[ Read More...





Calls for wider use of overdose antidote
Last Updated: 15-10-2014
Medical experts say the lifesaving drug naloxone must become widely available to reduce opioid overdoses. Health experts, researchers and practitioners are calling for a lifesaving antidote for victims of drug overdoses to be more widely used in r Read More...





Call for Vic pharmacists to give flu jab
Date of Posting: 15-10-2014
Call for Victoria's government to allow pharmacists to give adult flu jabs in time for the 2015 influenza season. Victoria's community pharmacists could be providing adult flu jabs in time for the 2015 influenza season.[subscribe] The V Read More...





Toddler's family wants better ambo times
Date of Posting: 15-10-2014
Ambulance Victoria says a call about a drowning child was mistakenly made a lower priority, as the family calls for improvements to response times. The family of a toddler who drowned in the bath wants faster ambulance response times, but Ambulanc Read More...





Vic needs heatwave plan: auditor-general
Last Updated: 15-10-2014
As the temperature heats up, Victorian Auditor-General John Doyle says the state urgently needs an emergency heatwave plan. More people died during Victoria's 2009 heatwave than the Black Saturday bushfires, but the state still does not have a Read More...





Meningococcal kills toddler in north Qld
Date of Posting: 15-10-2014
The death of a toddler from meningococcal disease in Townsville has prompted a warning to react quickly to symptoms of the deadly illness. Public health authorities say the death of a toddler in north Queensland from meningococcal disease highligh Read More...





Scientists reprogram skin cells to help find a cure fo Alzheimer's
Date of Posting: 14-10-2014
Dr Lezanne Ooi, from the Illawarra Health and Medical Research Institute based at UOW, is at the forefront of an exciting new branch of neuroscience that converts donated human cells back to their original pluripotent stem cell state so that they can Read More...





Help ads aimed at NSW gambling addicts
Date of Posting: 13-10-2014
A new NSW government campaign is urging problem gamblers to reach out for help - before it's too late. You don't have to hit rock-bottom before you seek help with a gambling problem.[subscribe] That's the message driving the latest Read More...





Dementia scarier than cancer for over 50s
Last Updated: 13-10-2014
Older people are more fearful of developing dementia than they are of cancer, a new poll suggests. Two-thirds of people over the age of 50 fear they will develop the condition, while just one in 10 said they were frightened of getting cancer.[subs Read More...




Clots as bad as heart disease: experts
Last Updated: 13-10-2014
Australians need to be made aware of their risks of getting a blood clot and the dangers that can follow, say medical experts. Blood clots kill at least an estimated 40 Australians a day and should be regarded as important as heart disease and dia Read More...





GPs pledge to ban drug company visits
Date of Posting: 10-10-2014
A group of Australian doctors has pledged to ban pharmaceutical companies visiting their practices but the AMA says the campaign is misguided. About 100 doctors have pledged to ban visits from pharmaceutical companies but the Australian Medical As Read More...





Warrior image poses mental problems: ADF
Date of Posting: 10-10-2014
Vice Admiral Ray Griggs says while the nation's soldiers are undoubtedly warriors, the term comes with traditional baggage. The vice chief of the Australian Defence Force says viewing the nation's soldiers as "warriors" poses pro Read More...





Don't panic over Ebola scare, says AMA
Date of Posting: 10-10-2014
The Australian Medical Association says there is no need to over-react about a Cairns nurse's Ebola scare. There's no need to panic or over-react due to the latest Ebola scare, the Australian Medical Association says.[subscribe] Cairns Read More...





First artificial hand with a sense of feel
Date of Posting: 09-10-2014
Two men have told US researchers that implanted electrodes in their artificial hands have allowed them to feel certain objects. Scientists are moving closer to an artificial hand that can feel.[subscribe] Implanted electrodes have allowed some Read More...





NSW dementia sufferers set to double
Last Updated: 09-10-2014
Western Sydney and coastal regions will be the areas in NSW most heavily impacted by dementia: study growth rates, new dementia prevalence rates show. The number of elderly people in NSW with dementia will more than double over the next 40 years, Read More...





People with dementia remember emotion
Last Updated: 09-10-2014
People with dementia remember the feelings associated with an event for a longer time, a study says, feeling the emotion after the memory has vanished. Although people with Alzheimer's disease forget things quickly, they can remember the feeli Read More...





Smart wearable body sensors for patient self-assessment and monitoring
Last Updated: 09-10-2014
Innovations in mobile and electronic healthcare are revolutionizing the involvement of both doctors and patients in the modern healthcare system by extending the capabilities of physiological monitoring devices [1,2]. Expansion of health information Read More...





NSW emergency to flood under GP co-payment
Date of Posting: 08-10-2014
About 500,000 extra people will go to emergency departments to avoid a GP co-payment, with an added cost of $80 million, NSW opposition claims. Emergency departments in NSW will be flooded with an extra half a million people a year if the federal Read More...





Coffee drinking 'is in your genes'
Date of Posting: 08-10-2014
A large study has found genetic links that may explain why a given amount of coffee or caffeine has different effects on different people. People's coffee-drinking habits are linked to their genes, scientists say.[subscribe] A large-scale s Read More...





Woman with womb transplant marvels at baby
Date of Posting: 08-10-2014
A Swedish woman who gave birth after a womb transplant has brushed off the stresses of caring for a newborn as she marvels at her miracle baby. The parents of the first baby born to a woman who had a womb transplant say they hope they can be an in Read More...





Dietitians respond to celebrity chef attack
Last Updated: 07-10-2014
It may focus on fresh fruit and vegetables but the Paleo diet fails to serve up all the nutrients our bodies need, as recommended in the revised Australian Dietary Guidelines (ADGs). Instead, the Paleo diet dishes up a high protein, high fat, low Read More...





Men give health the cold shoulder: study
Date of Posting: 07-10-2014
A Movember Foundation study finds men still have a way to go in taking their health and wellbeing seriously. Gather round gents and lean in lads, here's some advice: stop giving your health and wellbeing the cold shoulder.[subscribe] A stud Read More...





Nurse first Ebola victim outside Africa
Date of Posting: 07-10-2014
A Spanish nurse who treated two Ebola victims at a Madrid hospital has become the first person to contract the disease outside Africa. A Spanish nurse who treated two Ebola victims at a Madrid hospital has contracted the virus herself in the first Read More...





Anti-dengue mozzies released in Rio
Date of Posting: 03-10-2014
Brazil has begun releasing mosquitoes immunised against dengue fever in a bid to cut the number of people who contract the illness. Ten thousand mosquitoes immunised against dengue fever have been released in Brazil as part of an innovative attemp Read More...





Alcohol may reduce sperm quality: study
Date of Posting: 03-10-2014
The more alcohol men consume, the weaker the quality of their sperm, a study has found. Drinking just five units of alcohol every week could reduce the quality of a man's sperm, new research suggests.[subscribe] And the more alcohol consume Read More...





Date of Posting: 03-10-2014
Despite a long-standing immunisation program, whooping cough remains highly prevalent in Australia. WHAT IS WHOOPING COUGH?[subscribe] Pertussis, known more commonly as whooping cough, is a respiratory infection that causes a long coughing illnes Read More...





Being neurotic linked to Alzheimer's
Date of Posting: 03-10-2014
A 38-year study has found that neurotic women have a higher risk of developing Alzheimer's disease in later life, researchers say. Anxious, jealous, moody or distressed middle aged women may be putting themselves at risk of developing Alzheime Read More...





Kids get new hands made with 3D printer
Last Updated: 03-10-2014
A US surgeon has met the need for prosthetic hands in children by creating them on a 3D printer for about $20. When trauma surgeon Albert Chi gave a talk last year about advanced prosthetics and was asked what was easy, available and affordable, h Read More...





Combined cancer treatment hailed
Date of Posting: 02-10-2014
Combining immunotherapy and radiotherapy helps the immune system hunt down and destroy cancer cells not killed by the initial radiotherapy, a study says. Treating cancers with immunotherapy and radiotherapy at the same time could stop them becomin Read More...

Long-acting insulin safer, more effective
Date of Posting: 02-10-2014
Researchers say long-acting insulin significantly improves haemoglobin A1C levels, a measure of effective blood sugar control. Long-acting insulin is safer and more effective than intermediate-acting insulin for patients with Type 1 diabetes, acco Read More...




